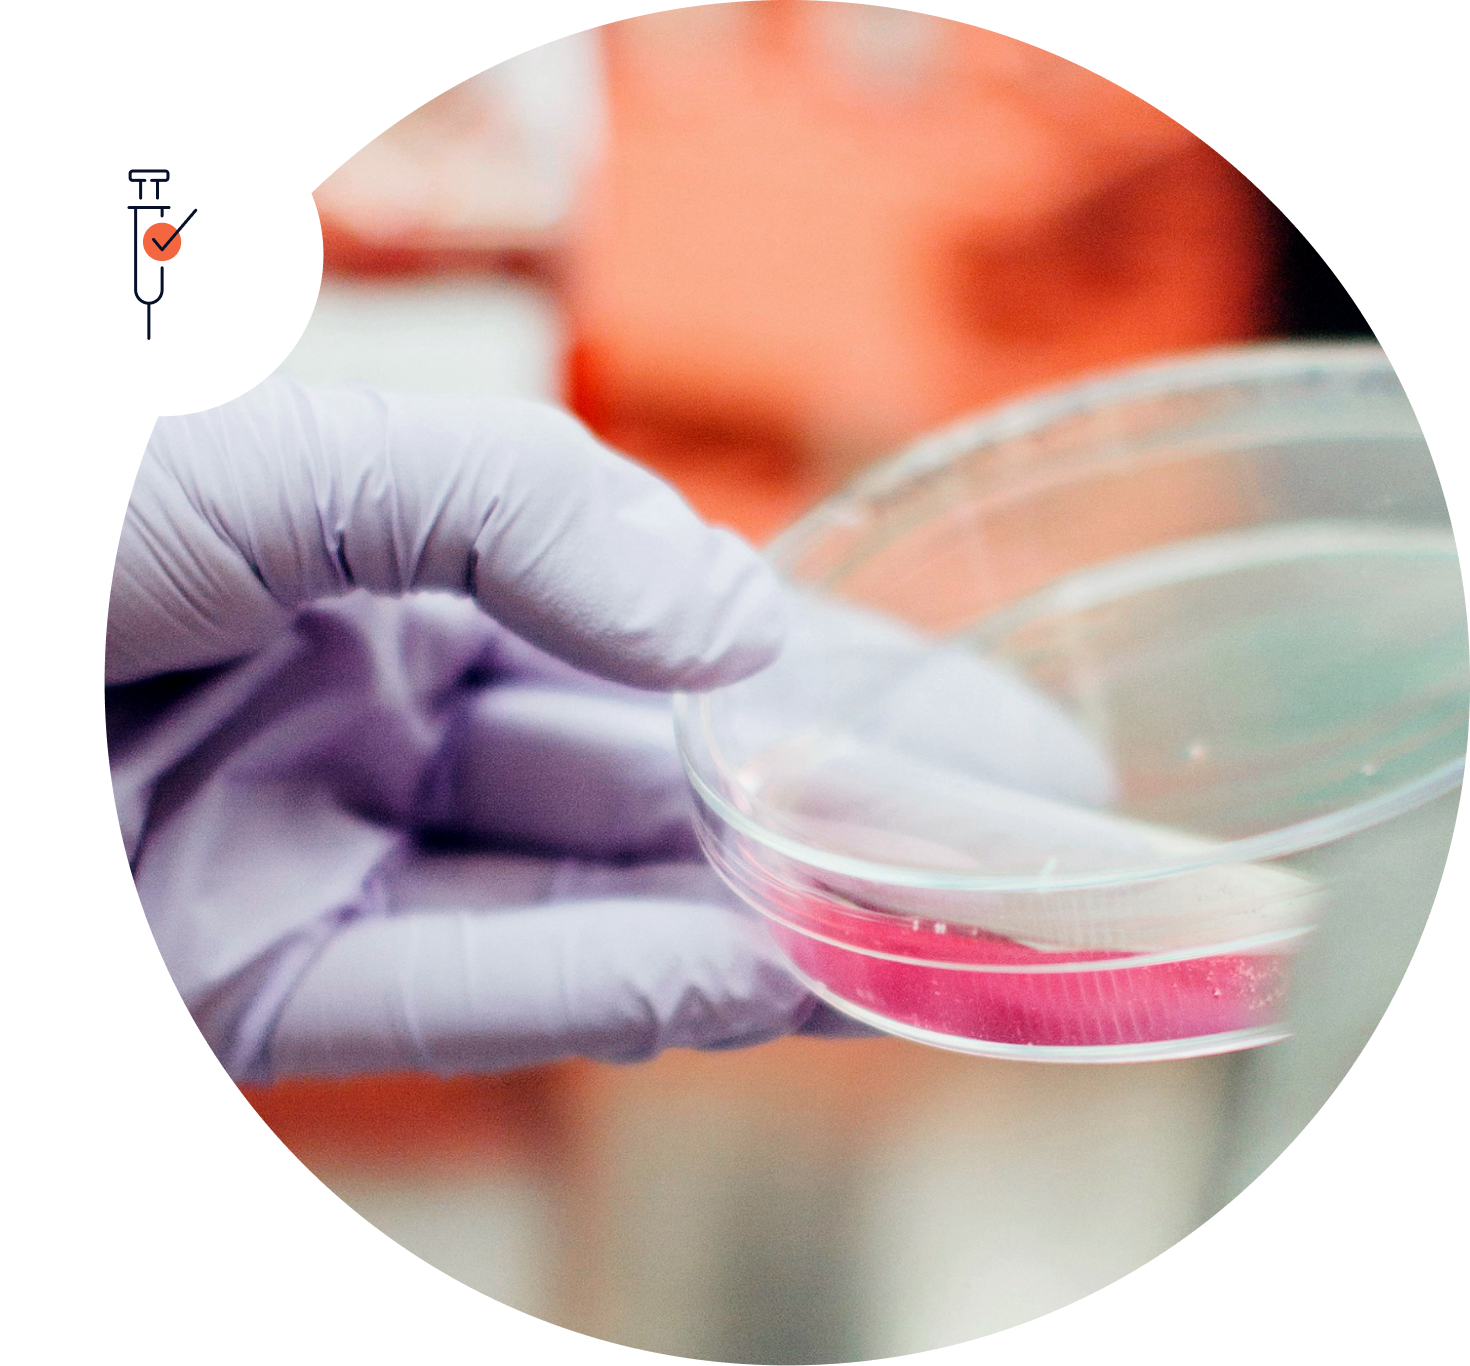

Our Cutting-edge Technology Platform
Combined with our deep R&D expertise, our platform fuels future innovation and partnerships.
Novavax’s proprietary technology platform has two key components:
What is Protein-based Nanoparticle Technology?

Novavax’s protein-based nanoparticles are made of engineered proteins that help trigger an immune response.1
Presenting multiple copies of a protein on the surface of each nanoparticle helps to enhance the immune response, resulting in vaccines that may work better.1
What is Matrix-M?

Matrix-M is an adjuvant – a substance added to a vaccine to stimulate a broader and stronger immune response. Matrix-M is made of naturally occurring compounds sustainably harvested from the bark of the Quillaja saponaria Molina tree.2
Matrix-M can be used to create vaccines for a variety of diseases to help tackle some of the world’s most pressing health challenges.
Protein-based Nanoparticles + Matrix-M
Synergistic Effects When Combined into One Powerful Platform
Combining Novavax’s protein-based nanoparticles with our Matrix-M adjuvant achieves strong, long-lasting and broad immune responses.2
Powering Innovation

Broad Application
Our platform has the potential to be used across a wide range of diseases.

Multi-Variant and Combination Potential
Different proteins from one pathogen or a combination from several pathogens have the potential to help protect against multiple variants or multiple diseases in a single vaccine.
Stability and Storage Advantages
Stability at standard refrigeration temperatures enables easier storage and transport for increased global access.5

Current Applications and Collaborations
Our technology platform is clinically proven with applications in two marketed vaccines used by people around the globe.

Our Pipeline
Our protein nanoparticle technology and Matrix-M adjuvant are the foundation of our diverse vaccine pipeline.

Partnerships
We forge dynamic collaborations to amplify the impact of our technology and pipeline.
- Nguyen B. Tolia N; Protein-based antigen presentation platforms for nanoparticle vaccines. NPJ Vaccines. 2021 May 13;6(1):70. doi: 10.1038/s41541-021-00330-7
- Stertman L. et al.; The Matrix-M™ adjuvant: A critical component of vaccines for the 21st century. Hum Vaccin Immunother. 2023 Dec 31;19(1):2189885. doi: 10.1080/21645515.2023.2189885.
- Pati R., et al.; Nanoparticle vaccines against infectious diseases. Front Immunol. 2018 Oct 4;9:2224. doi: 10.3389/fimmu.2018.02224
- Lozano D. et al.; An overview of the use of nanoparticles in vaccine development. Nanomaterials. 2023 Jun 9;13(12):1828. doi: 10.3390/nano13121828.
- Novavax COVID-19 Vaccine, Adjuvanted (2024-2025 Formula) EUA Fact Sheet for Healthcare Providers. Novavax Inc.; September 2024.
- Keech C. et al.; Phase 1-2 trial of a SARS-CoV-2 recombinant spike protein nanoparticle vaccine. New England Journal of Medicine. 2020 Dec 10;383(24):2320-2332. doi: 10.1056/NEJMoa2026920.
- WHO recommends R21/Matrix-M vaccine for malaria prevention in updated advice on immunization. News release. World Health Organization. Oct 2, 2023. Accessed Apr 15, 2025. https://www.who.int/news/item/02-10-2023-who-recommends-r21-matrix-m-vaccine-for-malaria-prevention-in-updated-advice-on-immunization